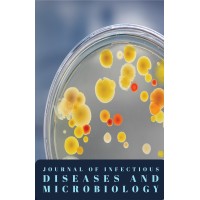
Journal of Infectious Diseases & Microbiology logo - Similar company to Asad Inc.

Company Details
- Employees
- 7
- Founded
- 2021
- Address
- 2 Simcoe St S, Oshawa,ontario L1h 8c1,canada
- Industry
- Medical And Diagnostic Laboratories
- NAICS
-
Medical and Diagnostic LaboratoriesMedical LaboratoriesDiagnostic Imaging Centers
- Website
- https://asad-inc.com/
- Keywords
- اقتصاد مدیا.
- HQ
- Oshawa, Ontario